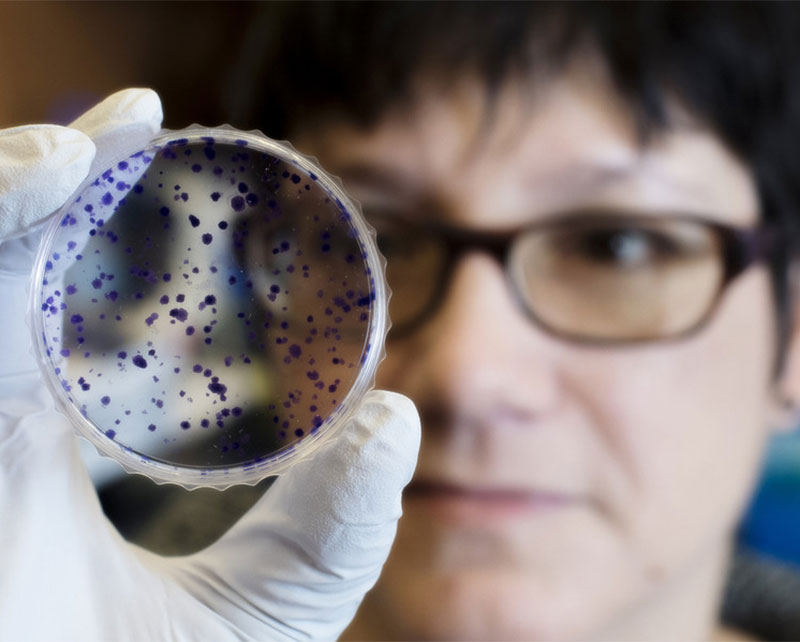
Heading 3

Grid Option 1
Widget type: Grid

Office of Sponsored Programs
The mission of the Office of Sponsored Programs (OSP) is to promote the initiatives of UAB as a premier research university and academic health center by providing effective guidance and support in the administration of sponsored projects. OSP enhances and facilitates the ability of faculty, staff, and students to achieve their goals through successful competition for external funding while maintaining responsible stewardship of these projects.

Human Research Protection Program
The UAB Human Research Protection Program (HRPP) is a committee established under federal regulations for the protection of human subjects in research (45 CFR 46). Its purpose is to help protect the rights and welfare of human participants in research conducted under the auspices of the University of Alabama at Birmingham.

Institutional Animal Care and Use Committee
The Institutional Animal Care and Use Committee (IACUC) oversees the use of animals for research, teaching, and testing conducted at or by UAB. The responsibility of the committee is to provide support, guidance, and oversight to research investigators and all staff working with and caring for animals in the animal use program while upholding the regulatory requirements and standards of federal and international oversight agencies. Compliance with international, federal, and university policies, regulations, and standards is important for animal welfare and continued financial support of the researchers and the university.

Animal Resources Program
Animal research at the University of Alabama at Birmingham is accredited by the Association for Assessment and Accreditation of Laboratory Animal Care International (AAALAC), is registered as a research facility with the United States Department of Agriculture (USDA), and has an has an Assurance of Compliance on file with the Public Health Service Office of Laboratory Animal Welfare (OLAW).

Research Development Office
The Research Development Office encompasses a set of strategic, proactive, catalytic, and capacity-building activities designed to facilitate individual faculty members, teams of researchers, and central research administrations in attracting extramural research funding, creating relationships, and developing and implementing strategies that increase institutional competitiveness. The RDO’s portfolio includes management and oversight of institutional centers and institutes.

Academic Research Organization for Clinical Trials (ARO-CT)
The UAB ARO-CT is responsible for a wide range of functions essential to clinical trial operations, including contracting, clinical billing review, financial services, regulatory affairs, industry relations and the OnCore clinical trials management system. By bringing these functions together under a single organization, the ARO-CT enables UAB to efficiently scale up clinical trials accruals by streamlining processes required for study startup and conduct.

Research Safety
The Office of Research Safety and Security is responsible for the implementation and management of several research-related safety committees including the Institutional Biosafety Committee (IBC), the Chemical Safety and Environmental Management Committee (CSEMC), the Radioisotope and Radiation Safety Committee (RRSC) and the committee for Dual Use Research of Concern (DURC).

Research Conflicts of Interest
The Office of Research Conflicts of Interest (RCOI) is charged with the ongoing development of procedures for identifying, reviewing, and managing financial conflicts of interest (FCOI) as they relate to extramurally-funded research and all research involving human subjects regardless of the funding source. Information about actual, potential or perceived financial conflicts of interests (FCOI) of UAB Investigators with research may be viewed on the RCOI web site under the COI policies tab.

Research Technology and Communications
The Research Technology and Communication office is responsible for administering IRAP research eRA system, managing the Office of Vice President for research websites, and communicating important information to the UAB research community.

Material Transfer Office
When you wish to receive tangible research materials from or send such materials to an external entity, you should work through the Material Transfer Office (MTO) to arrange a Material Transfer Agreement (MTA). The agreement addresses ownership of the transferred materials or research tools as well as any modifications or derivatives. The agreement also addresses limitations on the use of the material, confidentiality of information related to the materials, liability, publication rights, rights to inventions and research results, and other conditions of receipt or use.

Research Security and Export Control
UAB seeks to comply with applicable export control regulations in all University activities to further the creation and dissemination of knowledge for the public good while simultaneously protecting national security, align with current foreign policies, and protecting the U.S. economy and commerce. See the UAB Export Control Policy and the procedural document, UAB Export Control Program Plan.

Southeastern Biosafety Laboratory Alabama Birmingham (SEBLAB)
The regional biocontainment laboratory at UAB, called Southeastern Biosafety Laboratory Alabama Birmingham (SEBLAB), was completed in 2008 and fully operational in 2009. Located on the Southside of Birmingham on UAB's campus, SEBLAB is approximately 43,500 square feet. The project cost around $32 million to complete, with construction funding coming from the NIH and state sources.

Core Facility Directory
The Core Facility Directory lists registered organizations, both UWIRC-affiliated and independent. Core Facilities provide valuable services to the UAB Research community, and in many cases, outside UAB. For those organizations that have provided posters that summarize their services, you can click on the View Poster link and download the PDF.

Grid Option 2
Widget type: Grid

Heading 1
Lorem ipsum dolor sit amet
(205) 999-9999

Heading 2
Lorem ipsum dolor sit amet
(205) 999-9999

Heading 3
Lorem ipsum dolor sit amet
(205) 999-9999

Grid Option 3
Widget type: Grid

Grid Option 4
Widget type: Grid